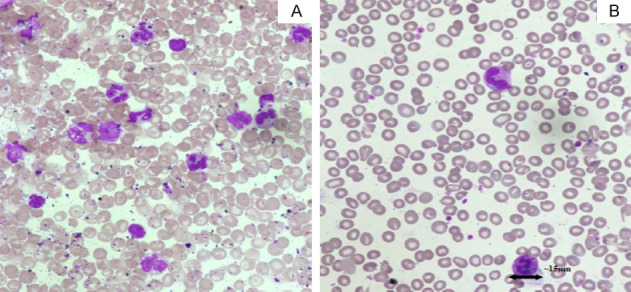

Ювенильный миеломоноцитарный лейкоз
Ювени́льный миеломоноцита́рный лейко́з (ЮММЛ) — это редкое клональное гемопоэтическое заболевание детского возраста, относящееся к миелопролиферативным новообразованиям и характеризующееся пролиферацией клеток гранулоцитарного и моноцитарного рядов. Клиническая картина обычно включает лихорадку, спленомегалию, тромбоцитопению и лейкоцитоз в периферической крови с моноцитозом, а также наличие лейкоэритробластической картины в мазке крови. У пациентов также могут наблюдаться кашель, кровянистый стул, эритематозная сыпь или задержка физического развития. Прогноз заболевания у большинства больных является крайне неблагоприятным в связи с ограниченной эффективностью существующих методов лечения[1][2].
История[править]
ЮММЛ впервые был описан в 1924 году[3].
Классификация[править]
Согласно классификации Всемирной организации здравоохранения ЮММЛ отнесён к группе миелодиспластических (миелопролиферативных) заболеваний[1].
Этиология[править]
Этиология ЮММЛ напрямую связана с генетическими мутациями, приводящими к гиперактивации сигнального пути Ras/MAPK. Подавляющее большинство пациентов (около 95%) имеют драйверные мутации в канонических генах этого пути. Основными при ЮММЛ являются мутации в генах PTPN11 (встречаются в 35-40% случаев), KRAS (~15%), NRAS (~15-20%), NF1 (~10-15%) и CBL (~10-15%). Эти мутации, как правило, являются взаимоисключающими. Важной особенностью этиологии ЮММЛ является высокая частота (до 25% случаев) наследственной предрасположенности. К развитию ЮММЛ предрасполагают такие синдромы, как нейрофиброматоз 1-го типа (герминальная мутация в гене NF1) и CBL-синдром (герминальная мутация в гене CBL), при которых лейкоз возникает после потери гетерозиготности в костном мозге. Синдром Нунан, вызываемый герминальными мутациями в генах PTPN11, SOS1, RAF1, KRAS и NRAS, также предрасполагает к миелопролиферативному заболеванию, которое может трансформироваться в ЮММЛ. Реже заболевание вызывается соматическими мутациями в других генах, таких как RRAS, RRAS2, SH2B3, а также химерными белками, возникающими в результате транслокаций с участием генов ALK, SOS1, FLT3 или PDGFRB[2].
Моносомия 7 хромосомы присутствует примерно у 25% пациентов с ЮММЛ и является наиболее частой кариотипической аномалией при этом заболевании. Другие цитогенетические аномалии могут быть обнаружены у дополнительных 10% пациентов. К ним относятся делеция хромосомы 5q и делеция длинного плеча хромосомы 7 (7q)[4].
Патогенез[править]
Патогенез ЮММЛ в своей основе имеет гиперактивацию сигнального пути Ras/MAPK, что приводит к гиперчувствительности клеток-предшественников к гранулоцитарно-макрофагальному колониестимулирующему фактору и их неконтролируемой пролиферации. Это ключевое биохимическое нарушение возникает вследствие драйверных мутаций в генах, регулирующих данный путь. Мутации в генах PTPN11, KRAS, NRAS, NF1 и CBL нарушают нормальный цикл активации/инактивации белка Ras, что приводит к его конститутивной активации в форме Ras-ГТФ. Белок Ras-ГТФ постоянно стимулирует нижележащие эффекторные каскады, такие как RAF/MEK/ERK и PI3K/Akt/mTOR, которые ответственны за пролиферацию, дифференцировку и выживание клеток. Ген NF1 кодирует белок нейрофибромин, который действует как ГТФаза-активирующий белок, ускоряющий инактивацию Ras; его мутация приводит к потере этой функции и накоплению активного Ras-ГТФ. Мутации в гене PTPN11, кодирующем тирозинфосфатазу SHP2, усиливают её активность, что также приводит к стойкой активации пути Ras. Мутации в гене CBL нарушают его роль негативного регулятора сигналинга, снимая тормозное влияние на активацию Ras. Таким образом, несмотря на разные точки приложения, все основные мутации при ЮММЛ конвергируют на одной молекулярной аномалии — хронической гиперактивации пути Ras, которая и является непосредственной причиной миелопролиферации[4].
Эпидемиология[править]
ЮММЛ составляет около 1% от всех детских лейкозов, с ежегодной заболеваемостью приблизительно 1,2 случая на миллион населения. Медианный возраст на момент диагностики составляет два года, при этом наблюдается преобладание среди мальчиков. Около трёх четвертей случаев диагностируется в возрасте до трёх лет, а к шести годам выявляется 95% всех случаев. ЮММЛ является наиболее частым подтипом миелопролиферативных новообразований у детей, на его долю приходится 20–40% таких диагнозов в педиатрической практике[4].
Диагностика[править]
Клиническая картина[править]
Пациенты с ЮММЛ могут иметь такие клинические проявления, как лихорадка, кашель, бледность, инфекции, спленомегалия, гепатомегалия, лимфаденопатия и кожная сыпь. Спленомегалия обнаруживается во всех случаях и является обязательным условием для постановки диагноза. Кожная сыпь и лимфаденопатия вызваны лейкемической инфильтрацией и наблюдаются примерно в 50% и 80% случаев соответственно. Кожные проявления включают экзему, ксантомы, пятна цвета кофе с молоком и ювенильную ксантогранулему. Поражение желудочно-кишечного тракта может проявляться в виде упорной диареи, геморрагических проявлений и инфекций. У таких пациентов может отмечаться кашель и респираторный дистресс-синдром. Хотя поражение центральной нервной системы при ЮММЛ встречается редко, описаны отдельные случаи с лейкемической инфильтрацией центральной нервной системы, глазной гранулоцитарной саркомой, несахарным диабетом и параличом лицевого нерва[4].
Лабораторные исследования[править]
Клинический анализ крови: характерно выявление анемии, лейкоцитоза, моноцитоза, сдвига гранулоцитарного ряда в сторону незрелых форм и тромбоцитопении. Присутствует сдвиг миелоидного ряда влево, при этом бластные клетки, включая промоноциты, составляют менее 5% от всех клеток. Характерна высокая концентрация фетального гемоглобина Тромбоцитопения также является частой находкой[4].
Микроскопия мазка крови: характерно выявление ядросодержащих эритроцитов[4].
Цитологическое исследования мазка костного мозга: наблюдается преобладание миелоидного ростка и гиперклеточность. Соотношение миелоидных к эритроидным клеткам может варьировать от 0,1 до более чем 94. Количество миелоидных предшественников, бластов, включая промоноциты, увеличено, но количество бластов составляет менее 20%. Палочки Ауэра не обнаруживаются. Моноциты составляют от 5% до 10% клеток костного мозга. Клетки эритроидного ростка имеют мегалобластоидный вид. Количество мегакариоцитов снижено[4].
Иммуноферментный анализ крови: характерно выявление гипергаммаглобулинемии[4].
Иммуногистохимическое исследование: моноцитарный компонент в аспирате костного мозга и в экстрамедуллярной ткани может быть выявлен с помощью иммуногистохимических маркеров, таких как CD14, CD11b, CD68R или лизоцим. В редких случаях миелопероксидаза может быть положительной при экстрамедуллярном поражении[4].
Цитогенетическое исследование: моносомия 7 хромосомы и другие цитогенетические аномалии могут быть выявлены при кариотипическом анализе[4].
Молекулярно-генетический анализ: мутации в генах NRAS, KRAS, PTPN11, CBL и NF1 могут быть выявлены с помощью методов геномного секвенирования[2][4].
Инструментальные исследования[править]
Компьютерная томография: возможно выявление инфильтратов в печени и лёгких[4].
Диагностические критерии[править]
Диагностические критерии Всемирной организации здравоохранения для ЮММЛ[4].
| Категория | Условие | Критерии |
|---|---|---|
| Категория 1
(Обязательны все критерии) |
Клинические и гематологические признаки | 1. Отсутствие химерного гена BCR-ABL1.
2. Количество циркулирующих моноцитов >1 × 10⁹/л. 3. Содержание бластных клеток в периферической крови и костном мозге <20%. 4. Спленомегалия. |
| Категория 2
(Достаточно одного критерия) |
Генетические исследования | 1. Соматическая мутация в генах KRAS, NRAS или PTPN11 (герминальные мутации должны быть исключены).
2. Клинический диагноз нейрофиброматоза 1-го типа или мутация в гене NF1. 3. Герминальная мутация в гене CBL и потеря гетерозиготности по этому гену. |
| Категория 3
(Для пациентов без генетических признаков из категории 2, кроме критериев категории 1 требуются следующие) |
Другие признаки | Наличие моносомии 7 или другой хромосомной аномалии или не менее двух из перечисленных ниже критериев:
|
Дифференциальная диагностика[править]
Дифференциальная диагностика ЮММЛ является сложной задачей, поскольку картина заболевания может имитироваться рядом других состояний. Вирусные инфекции, такие как цитомегаловирусная и вирус Эпштейна — Барр, могут вызывать цитопении, гепатоспленомегалию и моноцитоз, схожие с проявлениями ЮММЛ. В этих случаях ключевое значение имеют молекулярно-генетические исследования, так как обнаружение характерных для ЮММЛ мутаций в пути Ras подтверждает диагноз лейкоза. Кроме вирусных инфекций, в круг дифференциальной диагностики входят врождённые иммунодефицитный состояния (синдром Вискотта — Олдрича, дефект адгезии лейкоцитов), младенческий остеопетроз и гемофагоцитарный лимфогистиоцитоз. Отдельную группу составляют миелопролиферативные новообразования и лейкозы раннего детского возраста. Заболевания, ассоциированные с химерными генами рецепторных тирозинкиназ, могут иметь идентичную симптоматику. Острый лейкоз с перестройкой гена KMT2A также может быть клинически неотличим[4].
Особую сложность представляет дифференциация ЮММЛ от миелопролиферативного расстройства, ассоциированного с синдромом Нунан и другими патологиями, ассоциированными с мутациями в пути Ras. У младенцев с синдромом Нунан, вызванным герминальными мутациями в генах пути Ras (чаще всего в PTPN11), может развиться транзиторное миелопролиферативное заболевание, которое в тяжёлой форме полностью копирует картину ЮММЛ, но в большинстве случаев спонтанно регрессирует[4].
Лечение[править]
Тактика лечения строится на оценке риска, учитывая генетические особенности, возраст и концентрацию фетального гемоглобина. Часть пациентов с определёнными наследственными мутациями может находиться под наблюдением в ожидании возможной спонтанной ремиссии. Для облегчения симптомов у таких пациентов может применяться поддерживающая терапия. Пациенты с множественными мутациями, в возрасте старше года сразу направляется на интенсивную химиотерапию с последующей трансплантацией стволовых клеток. Ключевой задачей на предварительном этапе у этих пациентов является достижение молекулярной ремиссии до трансплантации, что значительно улучшает её исход[2].
Для большинства пациентов трансплантация остаётся единственным методом, способным привести к излечению. Наилучшие результаты демонстрирует трансплантация от полностью совместимого родственного или неродственного донора. Процедура сопровождается интенсивным кондиционированием, направленным на уничтожение остаточных опухолевых клеток. Успех трансплантации во многом зависит от реакции "трансплантат против опухоли", которую, однако, бывает сложно отделить от тяжёлого осложнения — реакции "трансплантат против хозяина"[2].
Прогноз[править]
Прогноз при ЮММЛ в целом является неблагоприятным, выживаемость после аллогенной трансплантации гемопоэтических стволовых клеток составляет около 50%. Течение заболевания и его исход существенно варьируют в зависимости от генетического подтипа. Например, для пациентов с мутацией в гене CBL характерен крайне вариабельный прогноз: у части больных может наблюдаться спонтанная ремиссия, в то время как у других развивается агрессивная форма лейкоза. Общим негативным прогностическим фактором является накопление множественных генетических аномалий. К благоприятным прогностическим признакам относятся возраст на момент дебюта, нормальная концентрация фетального гемоглобина, наличие герминальных мутаций и достижение ремиссии после трансплантации. К факторам высокого риска, ассоциированным с худшим прогнозом, относятся старший возраст пациента, высокая концентрация фетального гемоглобина, соматические мутации, сложные цитогенетические нарушения, генетические изменения, характерные для острого миелоидного лейкоза, а также рефрактерное течение или рецидив после трансплантации. Спонтанная регрессия заболевания наблюдается крайне редко и лишь у небольшой части пациентов[4].
Диспансерное наблюдение[править]
Пациенты с ЮММЛ нуждаются в наблюдении онколога и гематолога. Клинический анализ крови с детальной лейкоцитарной формулой проводится ежемесячно в первые три месяца после лечения, затем частота снижается до одного раза в полгода; этот мониторинг продолжается в течение пяти лет. Через шесть месяцев после окончания лечения выполняется комплексное молекулярно-биологическое исследование крови для исключения вирусных инфекций, включающее анализ на вирус иммунодефицита человека, антиген вируса гепатита B и антитела к вирусу гепатита C. Биохимический анализ крови (оцениваются концентрация альбумина, активность аланинаминотрансферазы, аспартатаминотрансферазы, лактатдегидрогеназы, концентрация общего и прямого билирубина, мочевины и креатинина) для контроля функции печени и почек, а также концентрации ферритина проводится один раз в год на протяжении пяти лет. Контроль состояния сердечно-сосудистой системы с помощью электрокардиографии и эхокардиографии осуществляется ежегодно в течение пятилетнего периода наблюдения. Для оценки зон возможного экстрамедуллярного поражения через шесть месяцев после завершения лечения выполняется визуализирующее исследование с помощью компьютерной или магнитно-резонансной томографии[5].
Профилактика[править]
Не разработана[5].
- ↑ 1,0 1,1 Хачатрян Л. А., Масчан М. А., Самочатова Е. В., и др. Дифференцировочная терапия с использованием 13-цис-ретиноевой кислоты и низких доз цитозин-арабинозида у детей с ювенильным миеломоноцитарным лейкозомрус. // Онкогематология. — 2008. — № 1-2.
- ↑ 2,0 2,1 2,2 2,3 2,4 Wintering A., Dvorak C. C., Stieglitz E., Loh M. L. Juvenile myelomonocytic leukemia in the molecular era: a clinician’s guide to diagnosis, risk stratification, and treatmentангл. // Blood Advances. — 2021. — том 5. — № 22. — С. 4783-4793. — DOI:10.1182/bloodadvances.2021005117
- ↑ Meynier S., Rieux-Laucat F. After 95 years, it’s time to eRASe JMMLангл. // Blood Reviews. — 2020. — том 43. — С. 100652. — DOI:10.1016/j.blre.2020.100652
- ↑ 4,00 4,01 4,02 4,03 4,04 4,05 4,06 4,07 4,08 4,09 4,10 4,11 4,12 4,13 4,14 4,15 Gupta A. K., Meena J. P., Chopra A. et al. Juvenile myelomonocytic leukemia-A comprehensive review and recent advances in managementангл. // American Journal of Blood Research. — 2021. — том 11. — № 1. — С. 1-21.
- ↑ 5,0 5,1 Российское общество детских онкологов и гематологов Острые миелоидные лейкозырусский. Министерство Здравоохранения Российской Федерации (28.01.2025). Проверено 7 февраля 2026.
Литература[править]
- Gupta A. K., Meena J. P., Chopra A., et al. Juvenile myelomonocytic leukemia-A comprehensive review and recent advances in managementангл. // American Journal of Blood Research. — 2021. — том 11. — № 1. — С. 1-21.
- Meynier S., Rieux-Laucat F. After 95 years, it’s time to eRASe JMMLангл. // Blood Reviews. — 2020. — том 43. — С. 100652. — DOI:10.1016/j.blre.2020.100652
- Wintering A., Dvorak C. C., Stieglitz E., Loh M. L. Juvenile myelomonocytic leukemia in the molecular era: a clinician’s guide to diagnosis, risk stratification, and treatmentангл. // Blood Advances. — 2021. — том 5. — № 22. — С. 4783-4793. — DOI:10.1182/bloodadvances.2021005117
- Хачатрян Л. А., Масчан М. А., Самочатова Е. В., и др. Дифференцировочная терапия с использованием 13-цис-ретиноевой кислоты и низких доз цитозин-арабинозида у детей с ювенильным миеломоноцитарным лейкозомрус. // Онкогематология. — 2008. — № 1-2.
Шаблон:Злокачественные гематологический заболевания миелоидного происхождения
Одним из источников, использованных при создании данной статьи, является статья из википроекта «Рувики» («ruwiki.ru») под названием «Ювенильный миеломоноцитарный лейкоз», расположенная по адресу:
Материал указанной статьи полностью или частично использован в Циклопедии по лицензии CC-BY-SA 4.0 и более поздних версий. Всем участникам Рувики предлагается прочитать материал «Почему Циклопедия?». |